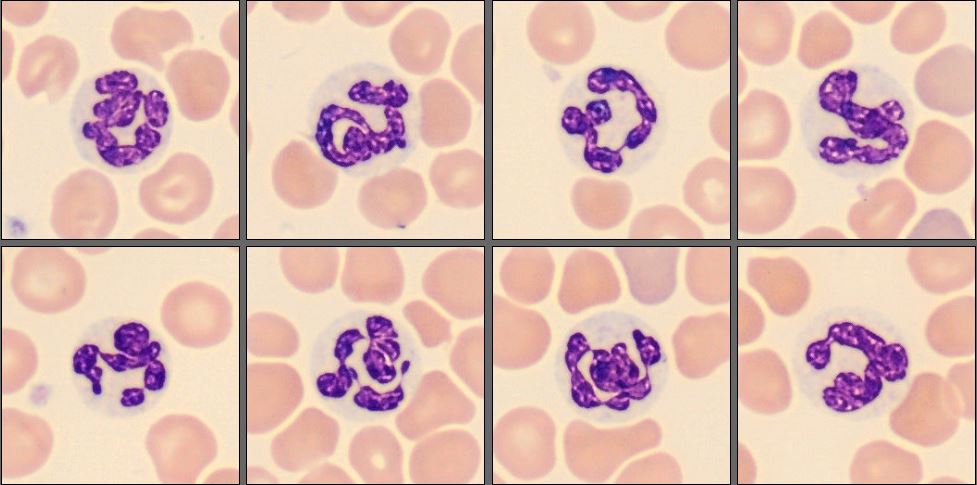
Neutrophils from the CellaVision Monthly Cell Challenge November 2025
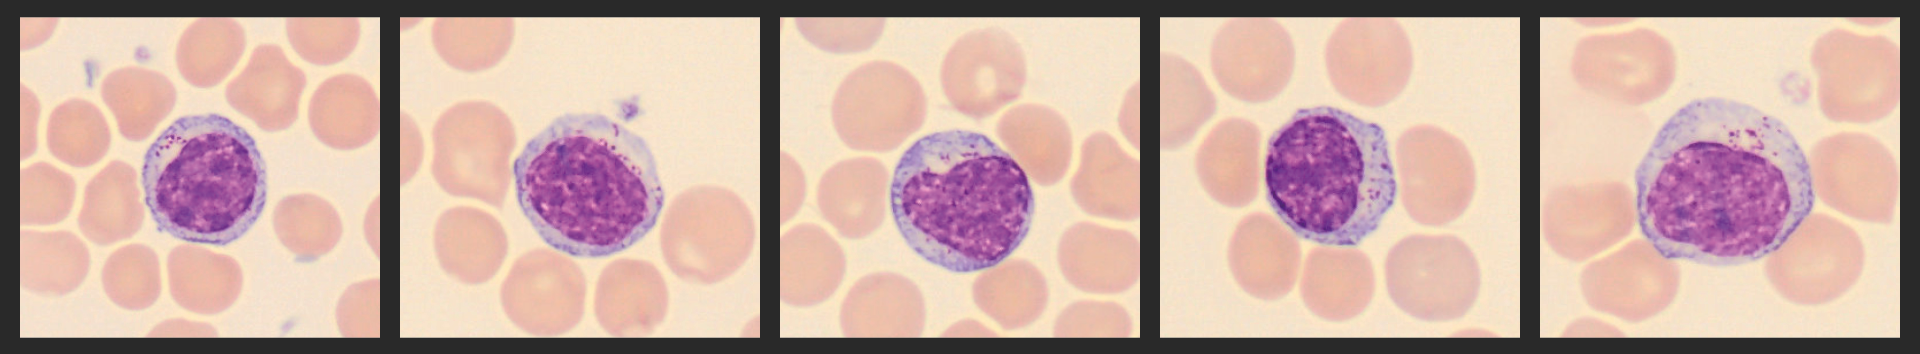
Cells from the Monthly cell challenge November 2025

Monthly Cell Challenge #11 / 2025

When Numbers Tell a Different Story
A 13-year-old spayed female dog was presented for her routine annual health check. She appeared bright, alert, and in good general condition, with no signs of fever or lymphadenopathy. As part of the senior wellness evaluation, the veterinarian decided to perform a complete blood count (CBC) and differential, and the results revealed something quite unexpected.
CBC results:
| Test | Result | Units | Ref |
|---|---|---|---|
| WBC | 122 | x109/L | (Ref: 5.05–16.76 x10^9/l) |
| HGB | 22,3 | L/L | (Ref: 37.3–61.7 l/l) |
| PLT | 297 | x109/L | (Ref: 148–484 x10^9/l) |
Smear review on CellaVision® DC-1
| WBC Differential | % | x109/L |
|---|---|---|
| Neutrophils | 5,9 | 7,2 |
| Eosinophils | 0,5 | 0,6 |
| Lymphocytes | 92,6 | 112,9 |
| Monocytes | 1,0 | 1,2 |

The CBC revealed a marked leukocytosis, accompanied by a decreased hematocrit and a normal platelet count.
The differential demonstrated a pronounced lymphocytosis, predominantly composed of small granular lymphocytes.
Red blood cell evaluation showed a normocytic and normochromic anemia with mild polychromasia and a few spherocytes were identified in the red cell population.
Diagnosis:
Chronic lymphocytic leukemia (CLL)
Discussion:
Chronic lymphocytic leukemia (CLL) in dogs is a hematopoietic neoplasm characterized by the clonal proliferation of small, mature lymphocytes within the bone marrow and peripheral blood. The disease most commonly affects middle-aged to older dogs and is often discovered incidentally during routine hematologic screening. Many affected dogs appear clinically normal at the time of diagnosis, which reflects the indolent nature of this disorder [1][3].
A particular morphological variant of CLL involves small granular lymphocytes (SGLs), which originate from cytotoxic T cells or natural killer (NK) cells. These lymphocytes are typically small to intermediate in size, with condensed chromatin and scant, pale cytoplasm that contains fine azurophilic granules [1][2]. The granular content corresponds to cytotoxic granules containing perforin and granzyme, reflecting the cytotoxic nature of these lymphocytes [2]. Morphologically, the cells appear uniform and well-differentiated, which supports a neoplastic rather than reactive process.
Dogs with granular lymphocytic CLL often exhibit marked and persistent lymphocytosis, sometimes exceeding 60 × 10⁹/L, while platelet counts and neutrophil numbers remain within normal limits. The bone marrow typically maintains its overall hematopoietic function. In some cases, a mild non-regenerative anemia is present, occasionally accompanied by spherocytes, suggesting an immune-mediated hemolytic component secondary to the neoplastic process [3].
Although smudge cells are commonly reported in human CLL, they are inconsistently observed in dogs and are usually considered artifacts of smear preparation rather than a diagnostic feature of CLL [1].
Immunophenotyping and molecular diagnostics play an important role in confirming the diagnosis. Flow cytometry or polymerase chain reaction for antigen receptor rearrangements (PARR) can determine clonality and immunophenotype. Most canine CLL cases with granular morphology are of T-cell (CD8⁺) lineage, although NK-cell phenotypes have also been reported [1][4]. This contrasts with the less common B-cell variant, which is typically non-granular and may follow a slightly different clinical course.
The clinical behavior of CLL involving SGLs is generally slow and indolent, although long-term monitoring is essential to detect potential disease progression or transformation. Many dogs remain asymptomatic for extended periods, and treatment is not always immediately required. When indicated, therapy with chlorambucil and prednisolone remains the standard treatment and is associated with good clinical responses and prolonged survival [4][5]. Median survival times range from one to three years, with some dogs maintaining stable disease for even longer periods [1][3].
This morphological variant illustrates how cytologic evaluation, in conjunction with clinical findings and immunophenotyping, can provide important diagnostic and prognostic insight in hematologic malignancies of dogs.
Reference:
[1] Workman HC, Vernau W. Chronic lymphocytic leukemia in dogs and cats: the veterinary perspective. Vet Clin North Am Small Anim Pract. 2003;33(6):1379-1399.
[2] Stokol T. Leukemia of granular lymphocytes in dogs. eClinpath. 2014. Available from: https://eclinpath.com/hematology/leukemia/leukemia-types/leukemia-of-granular-lymphocytes/
[3] Frontiers in Veterinary Science. Case report: Long-term survival of a dog with chronic lymphocytic leukemia. Front Vet Sci. 2021;8:625527. Available from: https://www.frontiersin.org/articles/10.3389/fvets.2021.625527/full
[4] Williams K. Chronic lymphocytic leukemia in dogs. VCA Animal Hospitals. 2022. Available from: https://vcahospitals.com/know-your-pet/chronic-lymphocytic-leukemia-in-dogs
[5] Brooks W. Lymphocytic leukemia in dogs. Veterinary Partner (VIN). 2007. Available from: https://veterinarypartner.vin.com/default.aspx?id=4952613&pid=19239